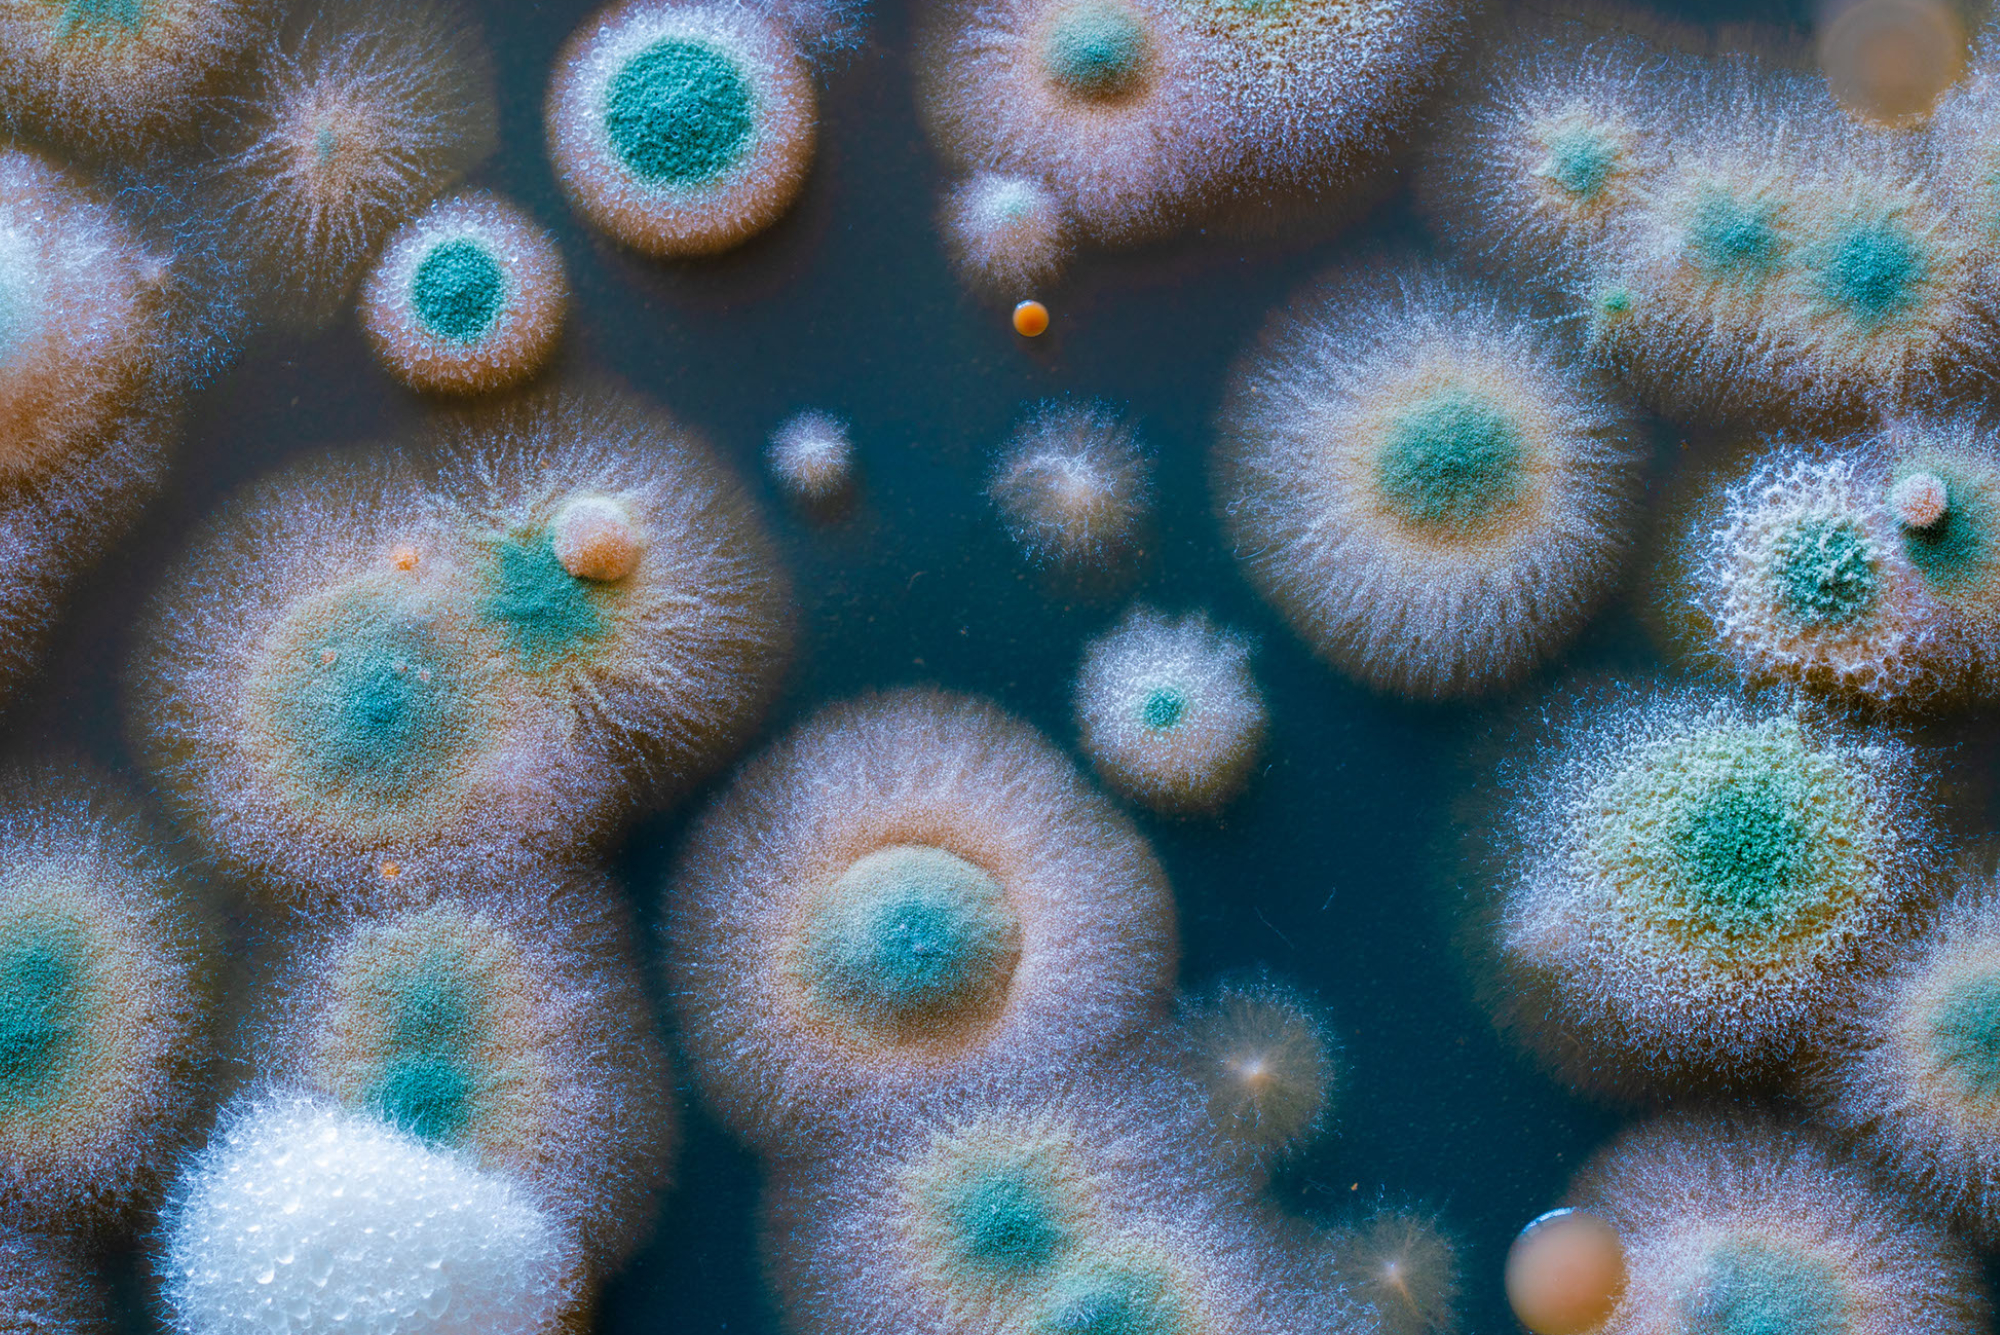

Effektive tiltak i kampen mot mugg
Admin
januar 21, 2023
Hvordan effektivt bekjempe mugg – tips og tiltak.
Ved synet av de karakteristiske tegn til innendørs soppdannelse kan det gå kaldt nedover ryggen hos de fleste. Muggsopp forringer estetikken og sågar det rammede inventaret. Videre truer dette helsen til både husstandens medlemmer og firbente kjæledyr. Her vil vi vise deg hvordan du blir kvitt mugg. Duis aute irure dolor in reprehenderit in voluptate velit esse cillum dolore eu fugiat nulla pariatur. Excepteur sint occaecat cupidatat non proident, sunt in culpa qui officia deserunt mollit anim id est laborum. Ut enim ad minim veniam, quis nostrud exercitation ullamco laboris nisi ut aliquip ex ea commodo consequat.
Hvorfor oppstår det mugg?
Innestengt luft og høy luftfuktighet er avgjørende faktorer for at denne helseskadelige soppen dannes og spres. Muggsopp kan merkes på den umiskjennelige, fuktige og ubehagelige eimen – videre oppdages fort mørke flekker og prikker på de overflatene som er infisert. Disse finnes som oftest i tak, rundt vindusåpninger og takskråninger, på møbler av tre og på matvarer.
Funn av muggsopp trenger dog ikke være grunn til panikk – å seire over muggsoppinfeksjoner er fullt mulig. Du kan benytte deg av spesialverktøy på egenhånd, og renholdsfirma, med spesialister som innehar de nødvendige relevante kunnskaper, ferdigheter samt lang erfaring, kan hjelpe deg med.
- Fleksibel og kostnadseffektiv
- Henvisningssystem
- Over 450 kunder
- Fornøydsgaranti
- Forsikring
- Miljøvennlig
- Utstyr av høy kvalitet
- 24/7 tilgjengelig for service
De vanligste typene muggsopp
Innenfor mykologien finner vi mange typer muggsopp. I det daglige møter vi som oftest bare noen få av dem:
- Hvitmugg – gartnere og plantevenner vil raskt oppdage denne typen, da den som oftest dukker opp i jordoverflaten i blomsterpotter samt på stilken til de tilhørende plantene. Et annet sannsynlig sted å finne hvitmugg er gamle bakervarer.
- Grønnmugg – oppstår ofte i akvarier og på steinflater. Denne typen påvirker ofte matvarer. Andre steder man kan finne grønnmugg er på elementene i vannforsyningssystem og vinduer, der kondens og lekkasjer gir grobunn.
- Blåmugg – møbler av tre skades av denne typen. Soppflekker ramponerer både utseendet og materialenes oppbygning.
- Svartmugg – denne typen er klart farligst. Svartmugg kan oppstå nærmest overalt og påvirker mat, treverk, tapet og faktisk fliser. Luftbårne sporer utgjør den største faren for åndedrettssystem.
Forebyggende tiltak
Muggdannelse er, som alle andre problemer, lettere å forhindre enn å håndtere. Det første som bør skje av forebyggende tiltak, er å installere en avfukter i rom med høy luftfuktighet.
Et annet effektivt tiltak i fuktige Oslo er daglig renhold og regelmessig ventilasjon. Du bør også sikre effektive og tilstrekkelig kraftige ventilasjonsanlegg. Deres tilførsel av frisk luft vil være en pålitelig barriere for spredning av mugg.
Hva gjør jeg hvis det dukker opp mugg?
Hvis muggsoppen har dannet små kolonier, er første steg å behandle de berørte overflatene med spesielle soppdrepende midler som kan kjøpes i spesialforretninger. De vil trenge dypt inn i materialets struktur og eliminerer sopp og sporer. For å utføre dette trygt og sikkert trenger du åndedrettsvern og hansker for å beskytte luftveier og hender. Hvis du ikke ønsker å utsette helsen og inventaret for unødvendig risiko og skade, vil fagfolk kunne hjelpe.
Siste innlegg
Trenger du hjelp?
Vårt team av ekspertrådgivere er klare til å gi deg sanntids assistanse og veiledning.



